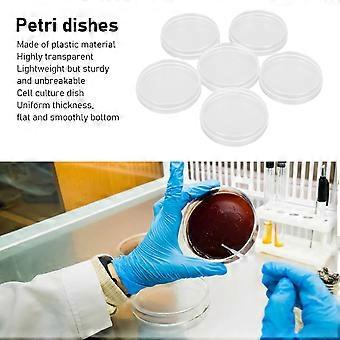
product image

20 قطعة أطباق بتري بلاستيكية معقمة مع غطاء 90 مم ضياء 15 مم طبق لوحة بتري مختبر عميق لتحليل زراعة بذور النبات
+ ٣٦٫٩٩ ر.س. الشحن
20 قطعة أطباق بتري بلاستيكية معقمة مع غطاء 90 مم ضياء 15 مم طبق لوحة بتري مختبر عميق لتحليل زراعة بذور النبات
- العلامة التجارية: Unbranded

20 قطعة أطباق بتري بلاستيكية معقمة مع غطاء 90 مم ضياء 15 مم طبق لوحة بتري مختبر عميق لتحليل زراعة بذور النبات
- العلامة التجارية: Unbranded
| سعر البيع القطاعي المقترح: | |
| السعر: | |
| أنت توفر: | ٢٠٫٠٠ ر.س. (22%) |
في المخزون
نقبل وسائل الدفع الآتية
الوصف
20 قطعة أطباق بتري بلاستيكية معقمة مع غطاء 90 مم ضياء 15 مم طبق لوحة بتري مختبر عميق لتحليل زراعة بذور النبات
- العلامة التجارية: Unbranded
- الفئة: أطباق بتري
- هوية Fruugo: 376849445-815122319
- EAN: 8461308299381
التسليم والرد
يُرسل خلال 24 ساعة
-
STANDARD: ٣٦٫٩٩ ر.س. - التسليم بين الجمعة 12 ديسمبر 2025 – الثلاثاء 23 ديسمبر 2025
يُشحن من الصين.
نحن نبذل قصارى جهدنا لضمان أن تصلك المنتجات التي تطلبها بالكامل وطبقاً المواصفات التي حددتها. إلا أنه في حال تلقيك طلب غير كامل أو أغراض تختلف عن تلك التي طلبتها أو كان هناك سبب آخر يدعوك لعدم الرضاء عن الطلب، فيمكنك رد الطلب أو أي منتجات يتضمنها الطلب واسترداد ما دفعته من أجل تلك الأغراض بالكامل. عرض سياسة الرد الكاملة
تفاصيل امتثال المنت
يرجى الاطلاع على معلومات الامتثال الخاصة بهذا المنتج الموضحة أدناه.
يتم توفير المعلومات التالية من قبل بائع التجزئة المستقل التابع لجهة خارجية الذي يبيع هذا المنتج.
الجهة المصنعة:
توضح المعلومات التالية تفاصيل الاتصال الخاصة بالجهة المصنعة للمنتج ذي الصلة والذي يُباع على Fruugo.
- shenzhenshijiangjunfudianzishangwuyouxiangongsi
- shenzhenshijiangjunfudianzishangwuyouxiangongsi
- BantianjiedaoxiangjiaotangshequzhonghaogongyechengC2dongwuceng505
- Longgangqu
- Shenzhenshi
- Guangdongsheng
- China
- 518000
- Wallace22578@outlook.com
- +8613084447403
الشخص المسؤول في الاتحاد الأوروبي:
توضح المعلومات التالية معلومات الاتصال الخاصة بالشخص المسؤول في الاتحاد الأوروبي. الشخص المسؤول هو المُشغل الاقتصادي المُعيّن والكائن في الاتحاد الأوروبي والمسؤول عن التزامات الامتثال المتعلقة بالمنتج ذي الصلة الذي يُباع داخل الاتحاد الأوروبي.
- SUCCESS COURIER SL
- SUCCESS COURIER SL
- CALLE RIO TORMES NUM.1.PLANTA 1,DERECHA.OFICINA3.Fuenlabrada.
- Madrid
- Spain
- 28947
- successservice2@hotmail.com
- +34910602659